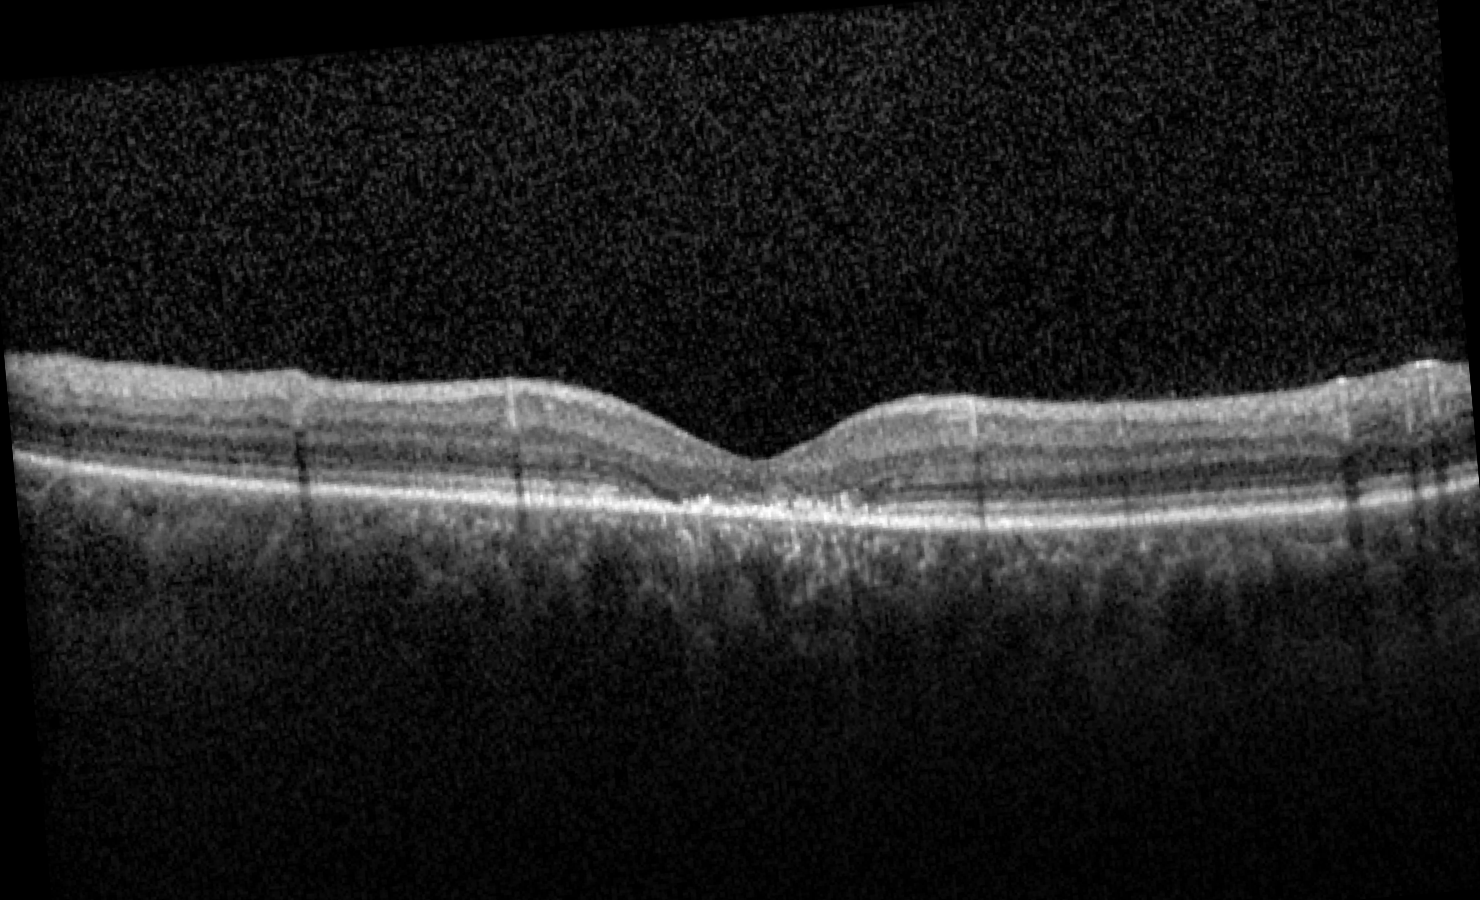

Big 14 Self-Assessment
Case 6
Case 6 is a 32 year old man with 20/150 visual acuity. He had relatively normal acuity as a young child but gradually lost vision after age 10. He is photophobic and cannot recognize any of the Ishihara pseudo-isochromatic plates. Two of his siblings as well as his mother and his maternal grandfather are all similarly affected.